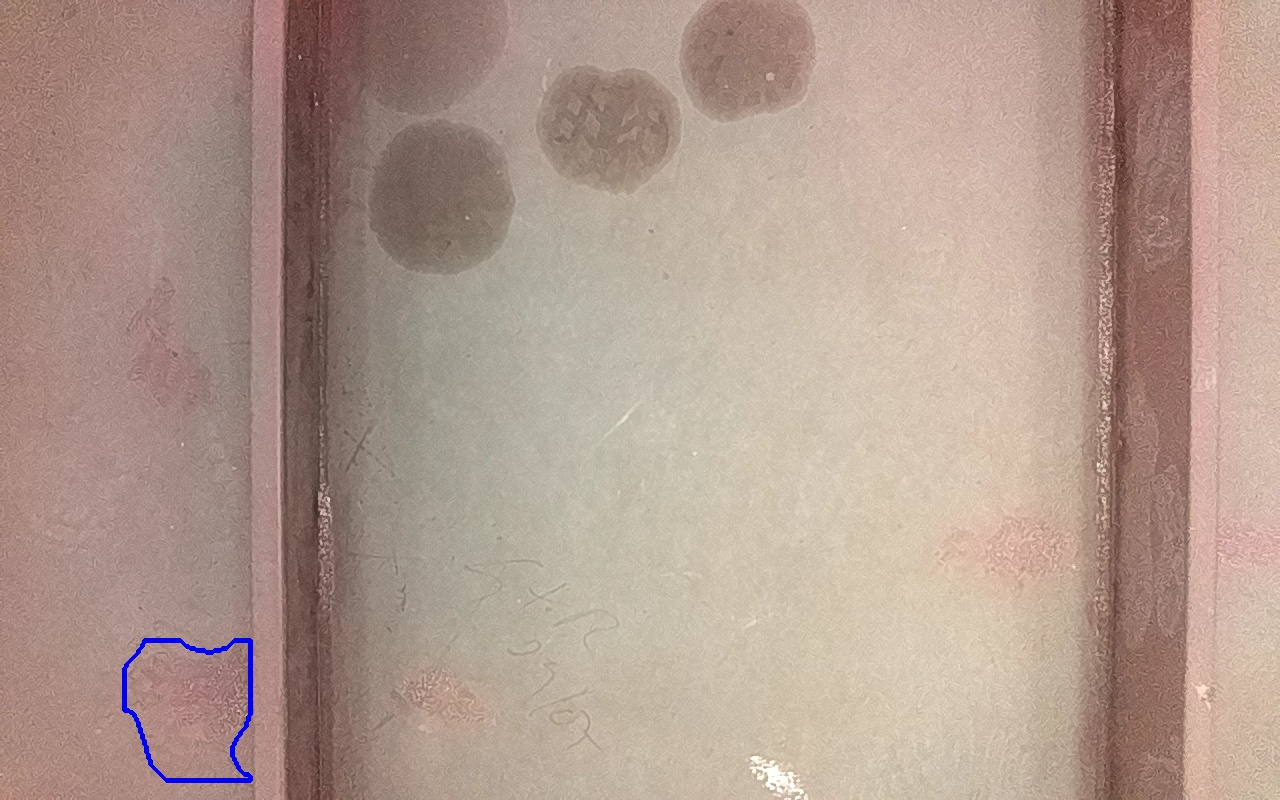

Discontinuidad detectada
| Tipo |
IV-1B
Rayaduras o zonas de metal expuestas con productos de óxido débilmente adherido. |
|---|---|
| Fecha | 25/06/2025 12:53 |
| Tamaño (mm) | 9366 mm2 |
| Tamaño (m) | 0.0094 m2 |
| Confianza | 11.23 % |
| Posición |
X: 2.41 Y: 0.19 Z: 0.02 |
| Resultado |